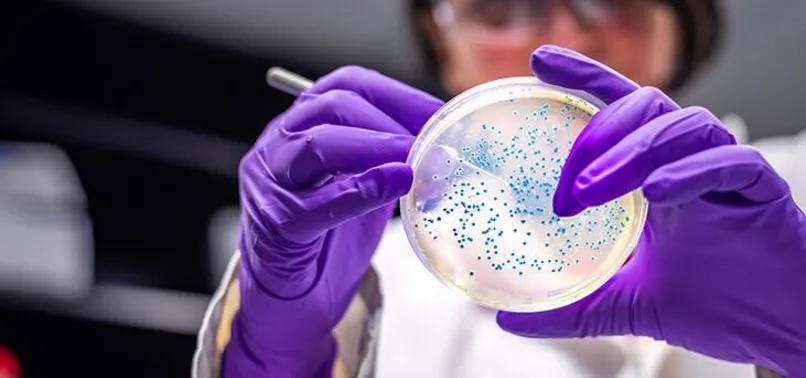

H5N8 alarmı! İlk kez hindide görüldü
Son dakika haberine göre; Tüm dünya koronavirüs salgını ile mücadele ederken Danimarka'da kuş gribi salgını patlak verdi. Ülkede Kasım 2020'den bu yana 8’inci defa kuş gribine rastlanırken, virüs ilk kez hindilerde tespit edildi.
Dünya koronavirüs salgını ile mücadele ederken Danimarka'da kuş gribi alarmı verildi. Ülkede ilk defa hindilerde kuş gribi tespit edildi. Bir çiftlikte kuş gribi virüsü (H5N8) tespitinin ardından 4 bin hindinin itlaf edilmeye başlandığı bildirildi. Gıda ve Kontrol İdaresinden yapılan açıklamaya göre, başkent Kopenhag'a 120 kilometre uzaklıktaki Skaelskör kasabası yakınlarında yer alan Lundby köyünde, yaklaşık 50 bin hindi bulunan bir çiftlikte kuş gribi virüsüne rastlandı.

4 BİN HİNDİ İTLAF EDİLİYOR
Hindilerin geniş bir alanda birbirine uzak 10 farklı kümeste yetiştirildiği çiftlikte, kuş gribi virüsü taşıyan hayvanların tespit edildiği tek kümesteki 4 bin hindinin itlafına başlandı.

Söz konusu çiftlik ile 3,5 kilometre ve 9 kilometre sınırındaki kümes hayvanları izlenmeye başlanırken, bölgede bazı önlemler alındı.

YUMURTA SATIŞI YASAKLANDI
Önlemler arasında, belirtilen sınırlar içerisindeki kümes hayvanlarının yer değiştirmesi ve yumurta satışının yasaklanması bulunuyor. Danimarka'da Kasım 2020'den bu yana 8'inci defa kuş gribine rastlanırken, virüs ilk kez hindilerde tespit edildi.






